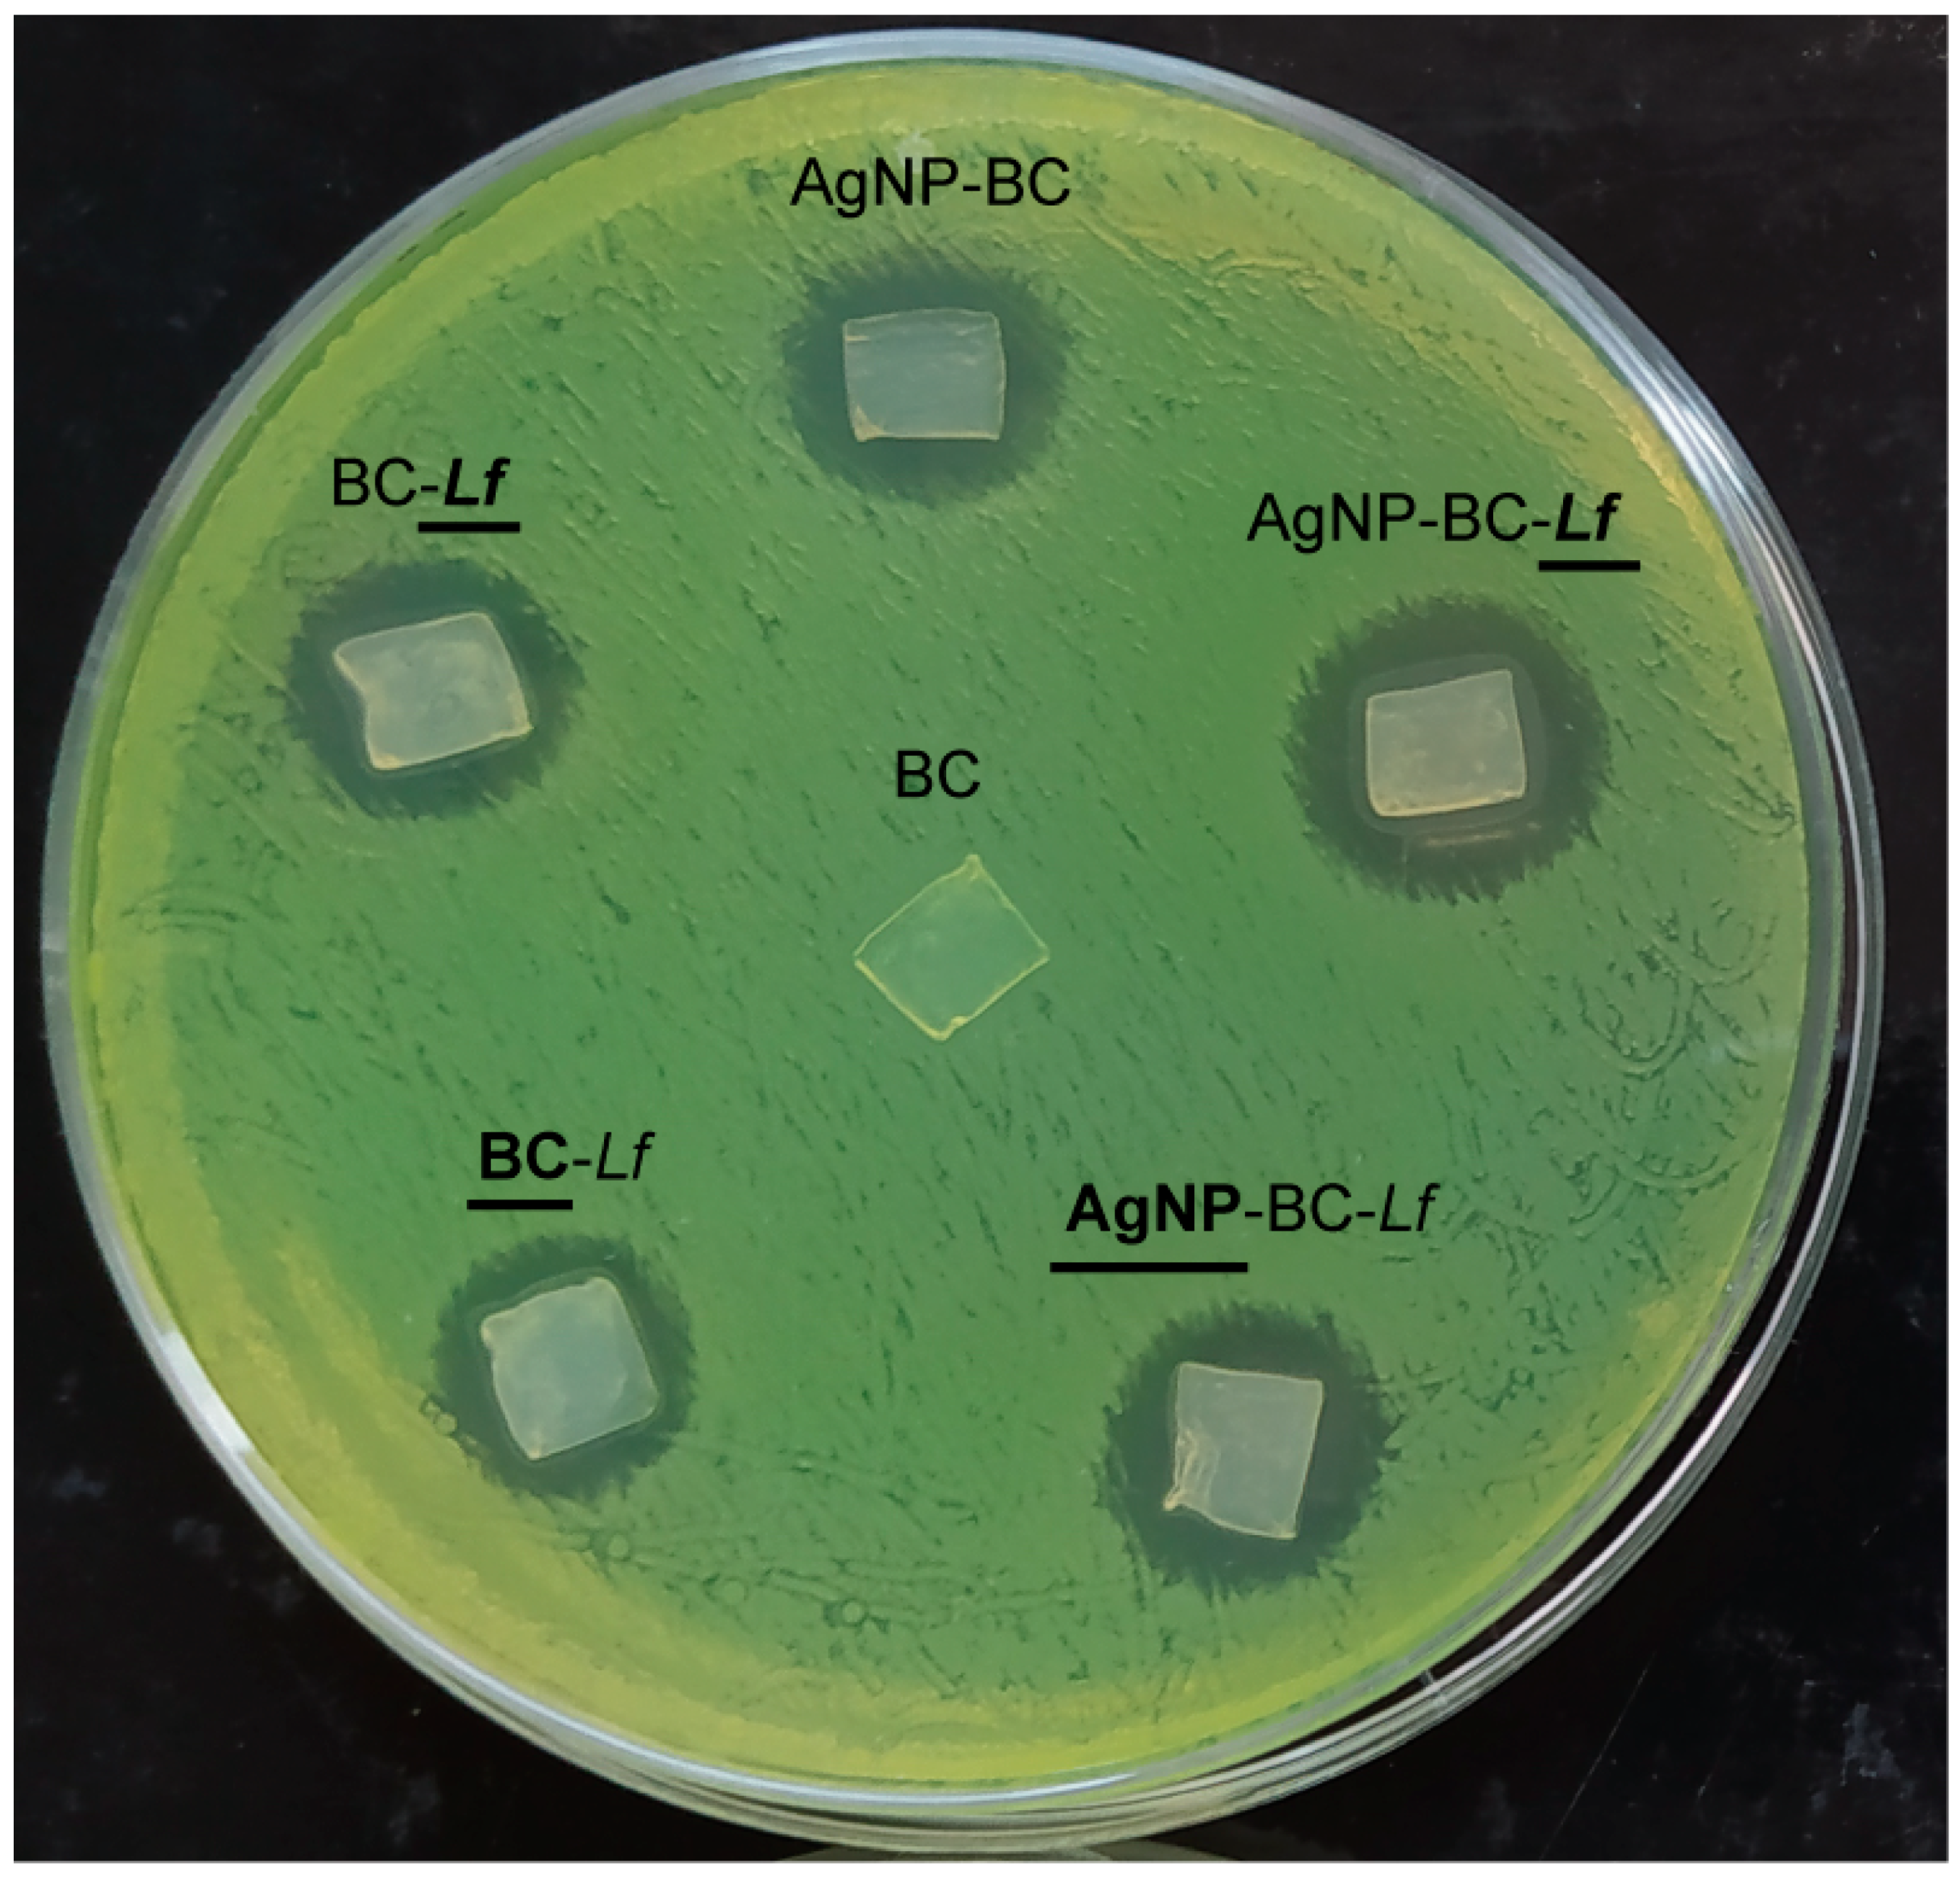
Molecules 26 02848 g004 Molecules 26 02848 g004

Two-Sided Antibacterial Cellulose Combining Probiotics and Silver Nanoparticles
Abstract
1. Main
2. Materials and Methods
2.1. Reagents and Solutions
2.2. Synthesis of Silver Nanoparticles
2.3. Bacteria Culture
2.4. Synthesis of Bacterial Cellulose
2.5. Incorporation of Probiotics into BC
2.6. Incorporation of Silver Nanoparticles
2.7. Quantification of Immobilized Probiotics on BC
2.8. Field Emission Scanning Electron Microscopy (FESEM)
2.9. Bacterial Viability Assay
2.10. Antimicrobial Activity Studies: Agar-Diffusion Method
3. Conclusions
Author Contributions
Funding
Institutional Review Board Statement
Informed Consent Statement
Conflicts of Interest
Sample Availability
References
- Willyard, C. The Drug-Resistant Bacteria That Pose the Greatest Health Threats. Nature 2017, 543, 15. [Google Scholar] [CrossRef] [PubMed]
- Luo, H.; Yin, X.; Tan, P.; Gu, Z.; Liu, Z.; Tan, L. Polymeric Antibacterial Materials: Design, Platforms and Applications. J. Mater. Chem. B 2021, 9, 2802–2815. [Google Scholar] [CrossRef] [PubMed]
- Borjihan, Q.; Dong, A. Design of Nanoengineered Antibacterial Polymers for Biomedical Applications. Biomater. Sci. 2020, 8, 6867–6882. [Google Scholar] [CrossRef] [PubMed]
- Guo, Z.; Chen, Y.; Wang, Y.; Jiang, H.; Wang, X. Advances and Challenges in Metallic Nanomaterial Synthesis and Antibacterial Applications. J. Mater. Chem. B 2020, 8, 4764–4777. [Google Scholar] [CrossRef] [PubMed]
- Pryshchepa, O.; Pomastowski, P.; Buszewski, B. Silver Nanoparticles: Synthesis, Investigation Techniques, and Properties. Adv. Colloid Interface Sci. 2020, 284, 102246. [Google Scholar] [CrossRef] [PubMed]
- Zhu, Y.; Zhang, J.; Song, J.; Yang, J.; Xu, T.; Pan, C.; Zhang, L. One-Step Synthesis of an Antibacterial and pro-Healing Wound Dressing That Can Treat Wound Infections. J. Mater. Chem. B 2017, 5, 8451–8458. [Google Scholar] [CrossRef] [PubMed]
- Gao, C.; Wang, Y.; Han, F.; Yuan, Z.; Li, Q.; Shi, C.; Cao, W.; Zhou, P.; Xing, X.; Li, B. Antibacterial Activity and Osseointegration of Silver-Coated Poly(Ether Ether Ketone) Prepared Using the Polydopamine-Assisted Deposition Technique. J. Mater. Chem. B 2017, 5, 9326–9336. [Google Scholar] [CrossRef] [PubMed]
- Rizzello, L.; Pompa, P.P. Nanosilver-Based Antibacterial Drugs and Devices: Mechanisms, Methodological Drawbacks, and Guidelines. Chem. Soc. Rev. 2014, 43, 1501–1518. [Google Scholar] [CrossRef] [PubMed]
- Pal, S.; Nisi, R.; Stoppa, M.; Licciulli, A. Silver-Functionalized Bacterial Cellulose as Antibacterial Membrane for Wound-Healing Applications. ACS Omega 2017, 2, 3632–3639. [Google Scholar] [CrossRef]
- Zhang, G.; Liu, Y.; Gao, X.; Chen, Y. Synthesis of Silver Nanoparticles and Antibacterial Property of Silk Fabrics Treated by Silver Nanoparticles. Nanoscale Res. Lett. 2014, 9, 1–8. [Google Scholar] [CrossRef]
- De Moura, M.R.; Mattoso, L.H.C.; Zucolotto, V. Development of Cellulose-Based Bactericidal Nanocomposites Containing Silver Nanoparticles and Their Use as Active Food Packaging. J. Food Eng. 2012, 109, 520–524. [Google Scholar] [CrossRef]
- Kokura, S.; Handa, O.; Takagi, T.; Ishikawa, T.; Naito, Y.; Yoshikawa, T. Silver Nanoparticles as a Safe Preservative for Use in Cosmetics. Nanomed. Nanotechnol. Biol. Med. 2010, 6, 570–574. [Google Scholar] [CrossRef]
- Chernousova, S.; Epple, M. Silver as Antibacterial Agent: Ion, Nanoparticle, and Metal. Angew. Chem. Int. Ed. 2013, 52, 1636–1653. [Google Scholar] [CrossRef] [PubMed]
- Panáček, A.; Kvítek, L.; Smékalová, M.; Večeřová, R.; Kolář, M.; Röderová, M.; Dyčka, F.; Šebela, M.; Prucek, R.; Tomanec, O.; et al. Bacterial Resistance to Silver Nanoparticles and How to Overcome It. Nat. Nanotechnol. 2018, 13, 65–71. [Google Scholar] [CrossRef]
- Vuotto, C.; Longo, F.; Donelli, G. Probiotics to Counteract Biofilm-Associated Infections: Promising and Conflicting Data. Int. J. Oral Sci. 2014, 6, 189–194. [Google Scholar] [CrossRef] [PubMed]
- Tsiouris, C.G.; Tsiouri, M.G. Human Microflora, Probiotics and Wound Healing. Wound Med. 2017, 19, 33–38. [Google Scholar] [CrossRef]
- González, A.; Sabio, L.; Hurtado, C.; Ramírez-Rodríguez, G.B.; Bansal, V.; Delgado-López, J.M.; Dominguez-Vera, J.M. Entrapping Living Probiotics into Collagen Scaffolds: A New Class of Biomaterials for Antibiotic-Free Therapy of Bacterial Vaginosis. Adv. Mater. Technol. 2020, 5, 2000137. [Google Scholar] [CrossRef]
- Tian, X.; Jiang, X.; Welch, C.; Croley, T.R.; Wong, T.Y.; Chen, C.; Fan, S.; Chong, Y.; Li, R.; Ge, C.; et al. Bactericidal Effects of Silver Nanoparticles on Lactobacilli and the Underlying Mechanism. ACS Appl. Mater. Interfaces 2018, 10, 8443–8450. [Google Scholar] [CrossRef] [PubMed]
- Picheth, G.F.; Pirich, C.L.; Sierakowski, M.R.; Woehl, M.A.; Sakakibara, C.N.; de Souza, C.F.; Martin, A.A.; da Silva, R.; de Freitas, R.A. Bacterial Cellulose in Biomedical Applications: A Review. Int. J. Biol. Macromol. 2017, 104, 97–106. [Google Scholar] [CrossRef]
- Czaja, W.; Krystynowicz, A.; Bielecki, S.; Brown, R.M., Jr. Microbial Cellulose—The Natural Power to Heal Wounds. Biomaterials 2006, 27, 145–151. [Google Scholar] [CrossRef]
- Homaeigohar, S.; Boccaccini, A.R. Antibacterial Biohybrid Nanofibers for Wound Dressings. Acta Biomater. 2020, 107, 25–49. [Google Scholar] [CrossRef] [PubMed]
- Bethke, K.; Palantöken, S.; Andrei, V.; Roß, M.; Raghuwanshi, V.S.; Kettemann, F.; Greis, K.; Ingber, T.T.K.; Stückrath, J.B.; Valiyaveettil, S. Functionalized Cellulose for Water Purification, Antimicrobial Applications, and Sensors. Adv. Funct. Mater. 2018, 28, 1800409. [Google Scholar] [CrossRef]
- Weishaupt, R.; Zünd, J.N.; Heuberger, L.; Zuber, F.; Faccio, G.; Robotti, F.; Ferrari, A.; Fortunato, G.; Ren, Q.; Maniura-Weber, K. Antibacterial, Cytocompatible, Sustainably Sourced: Cellulose Membranes with Bifunctional Peptides for Advanced Wound Dressings. Adv. Healthc. Mater. 2020, 9, 1901850. [Google Scholar] [CrossRef]
- Roig-Sanchez, S.; Jungstedt, E.; Anton-Sales, I.; Malaspina, D.C.; Faraudo, J.; Berglund, L.A.; Laromaine, A.; Roig, A. Nanocellulose Films with Multiple Functional Nanoparticles in Confined Spatial Distribution. Nanoscale Horiz. 2019, 4, 634–641. [Google Scholar] [CrossRef]
- Anton-Sales, I.; Roig-Sanchez, S.; Sánchez-Guisado, M.J.; Laromaine, A.; Roig, A. Bacterial Nanocellulose and Titania Hybrids: Cytocompatible and Cryopreservable Cell Carriers. ACS Biomater. Sci. Eng. 2020, 6, 4893–4902. [Google Scholar] [CrossRef]
- Sabio, L.; González, A.; Ramírez-Rodríguez, G.B.; Gutiérrez-Fernández, J.; Bañuelo, O.; Olivares, M.; Gálvez, N.; Delgado-López, J.M.; Dominguez-Vera, J.M. Probiotic Cellulose: Antibiotic-Free Biomaterials with Enhanced Antibacterial Activity. Acta Biomater. 2021, 124, 244–253. [Google Scholar] [CrossRef] [PubMed]
- Turkevich, J.; Stevenson, P.C.; Hillier, J. A Study of the Nucleation and Growth Processes in the Synthesis of Colloidal Gold. Discuss. Faraday Soc. 1951, 11, 55–75. [Google Scholar] [CrossRef]
- Schramm, M.; Hestrin, S. Factors Affecting Production of Cellulose at the Air/Liquid Interface of a Culture of Acetobacter Xylinum. J. Gen. Microbiol. 1954, 11, 123–129. [Google Scholar] [CrossRef] [PubMed]
- Khalid, A.; Khan, R.; Ul-Islam, M.; Khan, T.; Wahid, F. Bacterial Cellulose-Zinc Oxide Nanocomposites as a Novel Dressing System for Burn Wounds. Carbohydr. Polym. 2017, 164, 214–221. [Google Scholar] [CrossRef] [PubMed]

| Muestra | Inhibition Zones ± SD (mm2) |
|---|---|
| BC | 0 ± 0 a |
| AgNP-BC | 89 ± 2 b |
| BC-Lf | 81 ± 3 b |
| BC-Lf | 80 ± 2 b |
| AgNP-BC-Lf | 137 ± 9 c |
| AgNP-BC-Lf | 110 ± 10 c |
Publisher’s Note: MDPI stays neutral with regard to jurisdictional claims in published maps and institutional affiliations. |
© 2021 by the authors. Licensee MDPI, Basel, Switzerland. This article is an open access article distributed under the terms and conditions of the Creative Commons Attribution (CC BY) license (https://creativecommons.org/licenses/by/4.0/).
Share and Cite
Sabio, L.; Sosa, A.; Delgado-López, J.M.; Dominguez-Vera, J.M. Two-Sided Antibacterial Cellulose Combining Probiotics and Silver Nanoparticles. Molecules 2021, 26, 2848. https://doi.org/10.3390/molecules26102848
Sabio L, Sosa A, Delgado-López JM, Dominguez-Vera JM. Two-Sided Antibacterial Cellulose Combining Probiotics and Silver Nanoparticles. Molecules. 2021; 26(10):2848. https://doi.org/10.3390/molecules26102848
Chicago/Turabian StyleSabio, Laura, Andrea Sosa, José M. Delgado-López, and José M. Dominguez-Vera. 2021. "Two-Sided Antibacterial Cellulose Combining Probiotics and Silver Nanoparticles" Molecules 26, no. 10: 2848. https://doi.org/10.3390/molecules26102848
APA StyleSabio, L., Sosa, A., Delgado-López, J. M., & Dominguez-Vera, J. M. (2021). Two-Sided Antibacterial Cellulose Combining Probiotics and Silver Nanoparticles. Molecules, 26(10), 2848. https://doi.org/10.3390/molecules26102848

